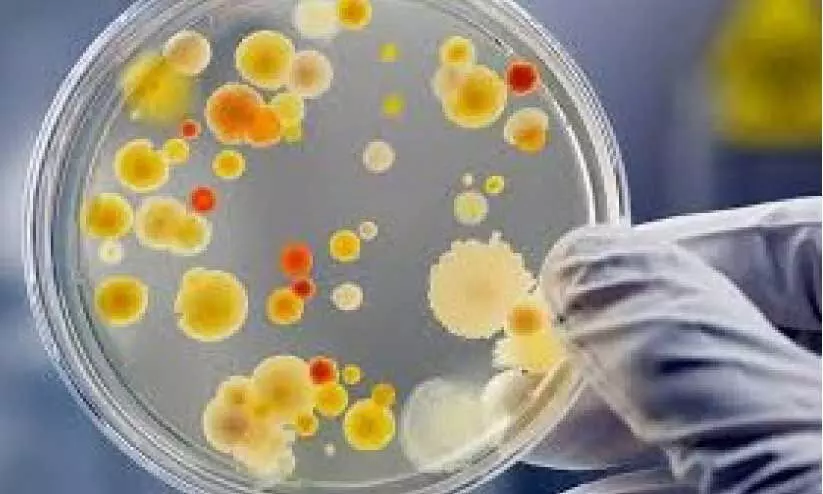

കുവൈത്ത് ഏറ്റവും കുറവ് അണുബാധ പടരുന്ന രാജ്യം
text_fieldsകുവൈത്ത് സിറ്റി: ആഗോളതലത്തില് ഏറ്റവും കുറവ് അണുബാധ പടരുന്ന രാജ്യങ്ങളിലൊന്നാണ് കുവൈത്തെന്ന് പകർച്ചവ്യാധി പ്രതിരോധ വകുപ്പ് ഡയറക്ടർ ഡോ.അഹമ്മദ് അൽ മുതവ. കഴിഞ്ഞ ദിവസം നടന്ന ശുചിത്വ കാമ്പയിനില് സംസാരിക്കുകയായിരുന്നു അദ്ദേഹം. നല്ല ആരോഗ്യത്തിലേക്കുള്ള ആദ്യപടിയാണ് സ്വയം ശുചിയാക്കി കൊണ്ടുള്ള കൈകഴുകൽ പ്രക്രിയ എന്ന് അദ്ദേഹം ഉണർത്തി. അണുബാധയുടെ വ്യാപനത്തെ ചെറുക്കുന്നതിനുള്ള ദേശീയ പരിപാടിയുടെ പ്രാധാന്യവും അദ്ദേഹം ചൂണ്ടിക്കാട്ടി. കൈ ശുചിത്വത്തിന്റെ പ്രാധാന്യത്തെക്കുറിച്ച് അവബോധം നല്കുന്നതിന്റെ ഭാഗമായി പ്രത്യേക കാമ്പയിൻ സംഘടിപ്പിക്കും. ഇതിന്റെ ഭാഗമായി രാജ്യത്തെ എല്ലാ ആശുപത്രികളിലും ആരോഗ്യ കേന്ദ്രങ്ങളിലും ബോധവത്കരണ പ്രവർത്തനങ്ങളും പരിപാടികളും സംഘടിപ്പിക്കുമെന്നും അറിയിച്ചു.
Don't miss the exclusive news, Stay updated
Subscribe to our Newsletter
By subscribing you agree to our Terms & Conditions.